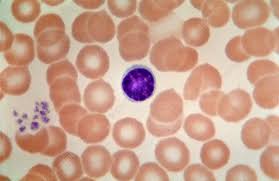
<p>provides immunity</p>

Blood, heart, and blood vessels (lab #12)
1/17
There's no tags or description
Looks like no tags are added yet.
Name | Mastery | Learn | Test | Matching | Spaced | Call with Kai |
|---|
No analytics yet
Send a link to your students to track their progress
18 Terms
red blood cells (erythrocytes)
transport oxygen
white blood cells
leucocytes
neutrophils
phagocytize bacteria

eosinophils (allergy)
release heparin & histamine

monocytes
phagocytize bacteria & larger material

lymphocytes
provides immunity
platelets (thrombocytes)
repair small holes in blood vessels

which WBC is the most abundant?
neutrophils
which WBC is the least abundant?
basophils
define hematocrit
% of total blood vol. made of RBCs
Rh (Rhesus factor)
inherited protein found on surface of red blood cells. determines if blood type is + or -having the protein makes you + , while lacking it makes you - .
what is blood pressure?
force of blood pushing against arteries
what is systolic?
pressure leaving heart
what is diastolic?
pressure in heart
normal blood pressure?
120/80
Do arterties hold their shape?
yes
what happens when you give someone the wrong blood type?
agglutination (makes it clump of RBC)
original terminology for BP cuff?
sphygmomanometer